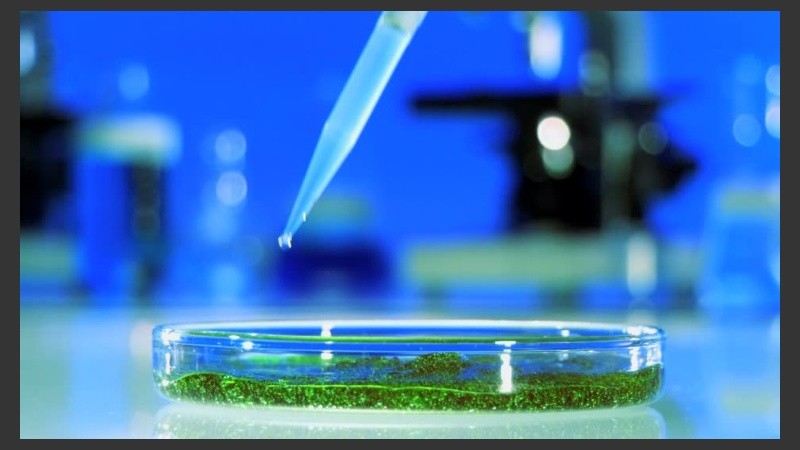
El primer premio por facultad será de $ 40.000.

El Ministerio de Ciencia, Tecnología e Innovación Productiva, junto con las facultades de Bioquímica y Ciencias Biológicas de la Universidad Nacional del Litoral (FBCB-UNL), y de Ciencias Bioquímicas y Farmacéuticas de la Universidad Nacional de Rosario (FCBF-UNR), convoca a participar del premio a las mejores tesinas de la Licenciatura en Biotecnología.
Esta iniciativa surge como una forma de reconocer y promover la generación del conocimiento en el área de la biotecnología. El objetivo es premiar a las mejores tesinas de grado desarrolladas por estudiantes de la carrera de Licenciatura en Biotecnología de la FBCB-UNL y de la FCBF-UNR que puedan contribuir al desarrollo regional.
La inscripción a participar se encuentra abierta hasta el 15 de septiembre. Podrán participar aquellos licenciados en Biotecnología que hayan aprobado su tesina de grado entre el 1 de junio de 2016 y el 31 de mayo de 2017. El primer premio por facultad es de $ 40.000, mientras que habrá dos menciones especiales de $ 20.000 cada una.
La biotecnología implica la aplicación de la ciencia y la ingeniería al empleo de organismos vivos o compuestos derivados de dichos organismos para generar productos y servicios que puedan resultar beneficiosos. Entre los productos se incluyen sustancias que permiten facilitar el diagnóstico, la prevención y el tratamiento de enfermedades humanas y animales; aumentar la productividad de los cultivos, controlar y hasta eliminar las plagas que los afectan; o reemplazar sustancias químicas, materiales y procesos que consumen fuentes no renovables o son peligrosas por su negativo impacto medioambiental y la generación de bioenergía.
Más info: www.fbioyf.unr.edu.ar | www.fbcb.unl.edu.ar